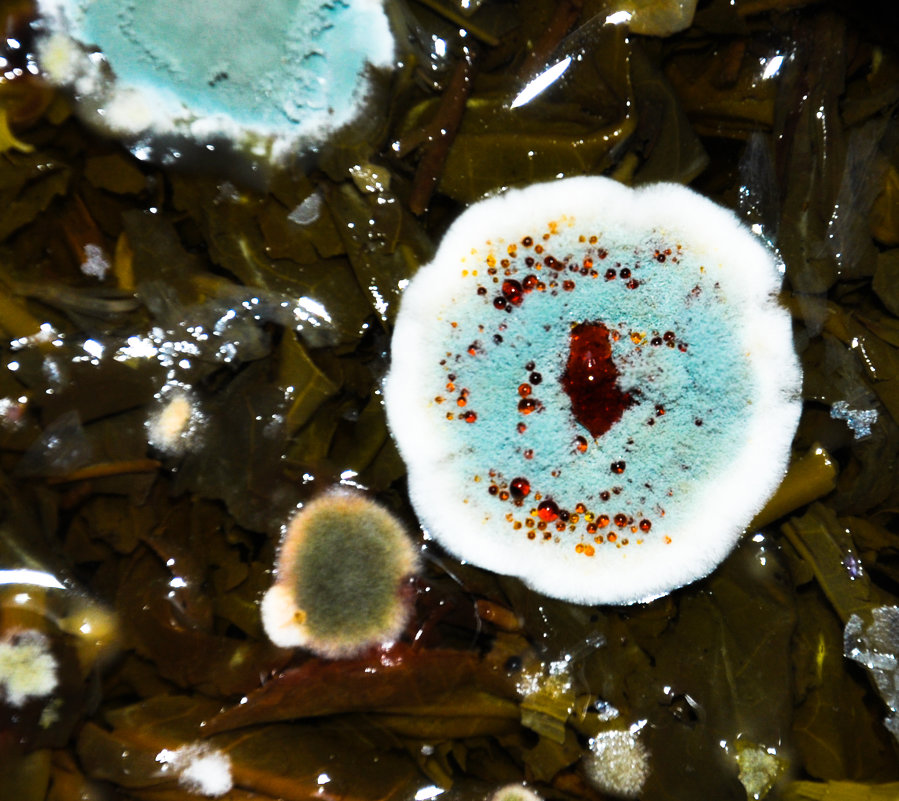
2818989.jpg

Заснешь от скуки тут начальство и застукает.Спокойной обстановки .

Хочу мороженое.:kuku:


Заснешь от скуки тут начальство и застукает.Спокойной обстановки .

еще работать и работатьХочу быстрее домой.
Чайка недовольна.Сам чайку испил бы.


Самому и готовить только ты уже устал.Вот теперь я хочу ужин
Будильник не дремлет.Спать,все
Подул легкий ветерок и вот я здесь.Пусть стихнет ветер,задолбал.


Потому что все нервы уже вымотали.День без нервов.


Пиратская копия тебе.Послеобеденный просмотр кино.
